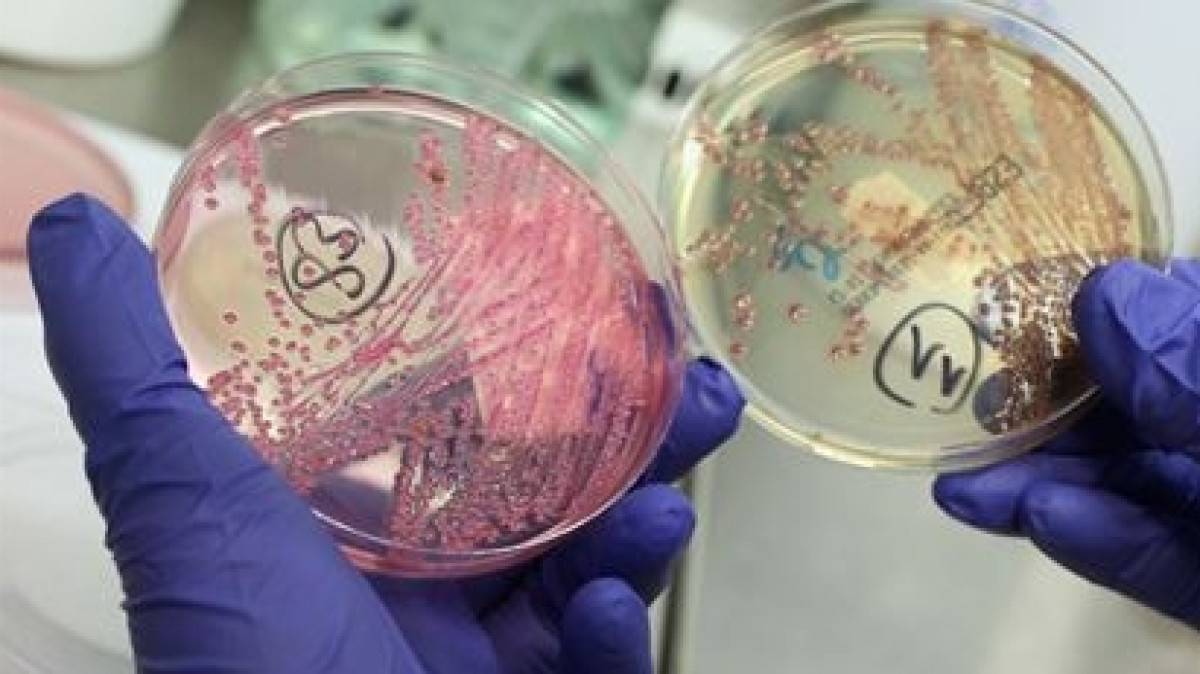
Из открытых источников

Очередной случай заболевания менингококковой инфекцией зарегистрирован в Астане. Об этом в ходе брифинга рассказал руководитель Департамента охраны общественного здоровья Астаны Садвакас Байгабулов, передаёт корреспондент BNews.kz.
1 октября в городскую инфекционную больницу в 20:40 часов был доставлен пациент с предварительным диагнозом "менингококковая инфекция". Уроженец Усть-Каменогорска (Восточно-Казахстанская область) прибыл из Жезказгана в Астану.
Известно, что недомогание мужчина почувствовал 29 сентября. Симптомы характеризовались, как сильные головные боли, головокружение, высокая температура. 30 сентября симптомы усилились, присоединилась рвота.
"Вместе с коллегой 1 октября они прибыли в Астану, остановились у друзей. Ему стало намного хуже 1 октября, в бессознательном состоянии мужчина 1985 года рождения был госпитализирован бригадой скорой медицинской помощи в инфекционную больницу города Астаны. В настоящее время на 4 октября общее состояние пациента улучшилось, он в сознании. Были опрошены контакты, прибыл вместе с коллегой, контактных - шесть человек. Это двое детей и четверо взрослых. В домашнем очаге проведены противоэпидемические мероприятия, проведена термометрия. У контактов не выявлена менингококковая инфекция", - рассказал Садвакас Байгабулов.
Он заявил, что 3 октября у мужчины был лабораторно подтверждён диагноз "менингококковая инфекция", был выделен менингококк. На данный момент проводится симптоматическое лечение пациента. Контактные лица будут находиться под наблюдением ещё около 12 дней.
"Пациент, который находится в городской инфекционной больнице, в течение двух недель состояние его стабилизируется, и он будет выписан", - добавил руководитель департамента.
О пациенте известно, что он занимается монтажом. В Жезказгане он проводил работы по установке сигнализации в банке РБК. Находился там с 13 по 30 сентября. По словам эксперта, учитывая инкубационный период, мужчина заразился именно в Жезказгане.
"Когда они ехали в Астану в машине их было двое человек: сам пациент и его коллега, житель Астаны. 2 октября мы направили извещение в Департамент охраны общественного здоровья по Карагандинской области, были направлены все данные, чтоб они провели противоэпидемические мероприятия в очаге, установили контактных и приняли соответствующие меры по локализации и исключению распространения менингококковой инфекции", - сказал Байгабулов.
Отметим, что менингококковая инфекция передаётся воздушно-капельным путём. Источником инфекции является сам больной или носитель.
В Астане цикличность менингококковой инфекции составляет 6-8 лет. Последняя вспышка была в 2015 году, тогда было зарегистрировано 211 случаев. По данным департамента, следующая вспышка ожидается в 2021-2023 годах.
Всего в Астане в 2018 году было зарегистрировано 7 случаев заражения менингококковой инфекцией, летальных случаев не было.
 Алина Шашкина
Алина Шашкина